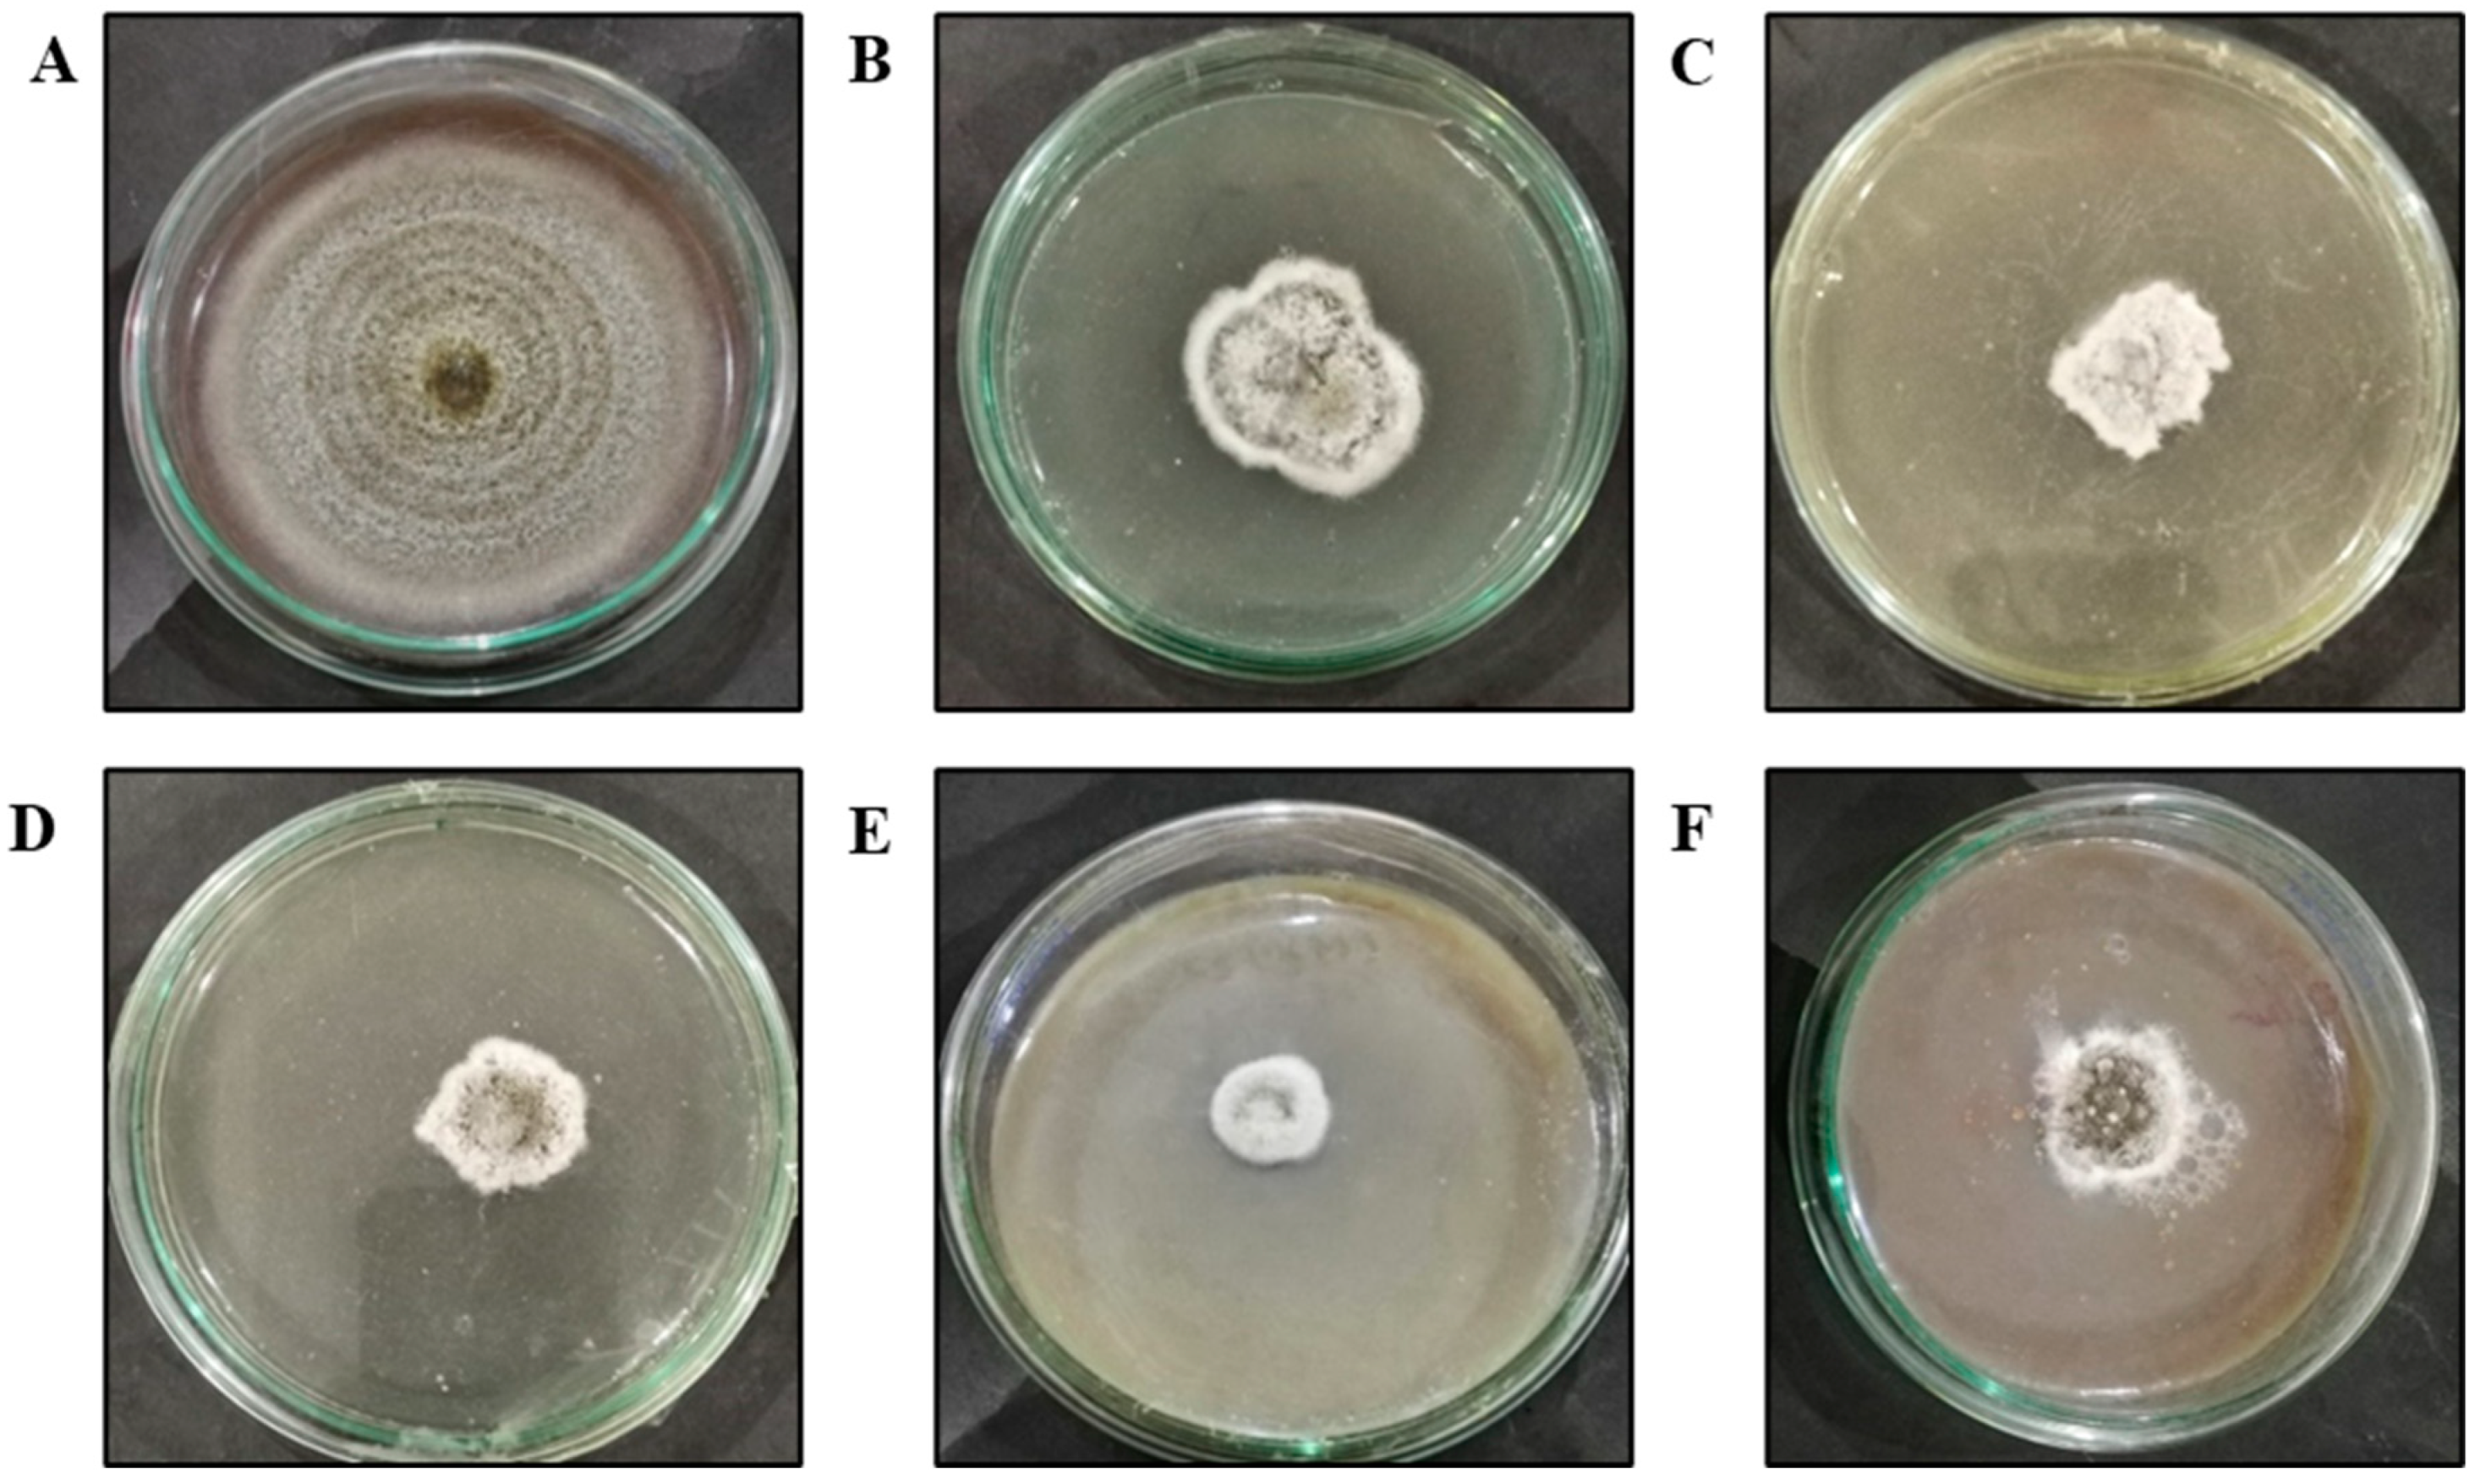

Antifungal Potential of Biogenic Zinc Oxide Nanoparticles for Controlling Cercospora Leaf Spot in Mung Bean
Abstract
1. Introduction
2. Materials and Methods
2.1. Collection of Plant Material
2.2. Pathogen Isolation and Confirmation of Pathogenicity
2.2.1. Pathogen Isolation and Identification
2.2.2. Detached Leaf Method
2.3. Synthesis of ZnO NPs Using Green Approach
2.4. Characterization of ZnO NPs Synthesized Using N. sativa
2.5. Antifungal Potential of ZnO NPs
2.6. Potential of ZnO NPs to Suppress Cercospora Leaf Spot in Mung Bean
2.6.1. Application of ZnO NPs in Pot Trials
2.6.2. Determination of Disease Severity Parameters
2.7. Effect of ZnO NPs on the Growth and Physiology of Mung Bean Plants
2.7.1. Analysis of the Plant Growth Parameters
2.7.2. Quantification of Total Chlorophyll (Chl) and Carotenoid Contents
2.8. Statistical Analysis
3. Results
3.1. Pathogen Isolation and Confirmation of Pathogenicity
3.2. Characterization of Green-Synthesized ZnO NPs
3.2.1. UV-Visible Spectroscopy
3.2.2. X-Ray Diffraction
3.2.3. Fourier-Transform Infrared Spectroscopy (FTIR)
3.2.4. Scanning Electron Microscopy
3.3. Analysis of the Antifungal Potential of ZnO NPs
3.4. Potential of ZnO NPs to Suppress Cercospora Leaf Spot in Mung Bean
3.5. Effect of ZnO NPs on the Growth and Physiology of Mung Bean Plants
3.5.1. Effect of ZnO NPs on the Growth of Mung Bean Plants
3.5.2. Effect of ZnO NPs on the Physiology of Mung Bean Plants
4. Discussion
5. Conclusions
Supplementary Materials
Author Contributions
Funding
Data Availability Statement
Conflicts of Interest
References
- Farahat, G. Biosynthesis of nano zinc and using of some nanoparticles in reducing of Cercospora leaf spot disease of sugar beet in the field. Environ. Biodivers. Soil Secur. 2018, 2, 103–117. [Google Scholar] [CrossRef]
- Ruszkiewicz, J.A.; Pinkas, A.; Ferrer, B.; Peres, T.V.; Tsatsakis, A.; Aschner, M. Neurotoxic effect of active ingredients in sunscreen products, a contemporary review. Toxicol. Rep. 2017, 4, 245–259. [Google Scholar] [CrossRef] [PubMed]
- Salem, N.M.; Awwad, A.M. Green synthesis and characterization of ZnO nanoparticles using Solanum rantonnetii leaves aqueous extract and antifungal activity evaluation. Chem. Int. 2022, 8, 12–17. [Google Scholar]
- Ashajyothi, C.; Prabhurajeshwar, C.; Handral, H.K. Investigation of antifungal and anti-mycelium activities using biogenic nanoparticles: An eco-friendly approach. Environ. Nanotechnol. Monit. Manag. 2016, 5, 81–87. [Google Scholar]
- Bhat, J.A.; Faizan, M.; Bhat, M.A.; Huang, F.; Yu, D.; Ahmad, A.; Bajguz, A.; Ahmad, P. Defense interplay of the zinc-oxide nanoparticles and melatonin in alleviating the arsenic stress in soybean (Glycine max L.). Chemosphere 2022, 288, 132471. [Google Scholar] [CrossRef] [PubMed]
- Sahoo, S.K.; Dwivedi, G.K.; Dey, P.; Praharaj, S. Green synthesized ZnO nanoparticles for sustainable production and nutritional biofortification of green gram. Environ. Technol. Innov. 2021, 24, 101957. [Google Scholar] [CrossRef]
- Li, S.; Liu, J.; Wang, Y.; Gao, Y.; Zhang, Z.; Xu, J.; Xing, G. Comparative physiological and metabolomic analyses revealed that foliar spraying with zinc oxide and silica nanoparticles modulates metabolite profiles in cucumber (Cucumis sativus L.). Food Energy Secur. 2021, 10, e269. [Google Scholar] [CrossRef]
- Sabir, S.; Zahoor, M.A.; Waseem, M.; Siddique, M.H.; Shafique, M.; Imran, M.; Hayat, S.; Malik, I.R.; Muzammil, S. Biosynthesis of ZnO nanoparticles using bacillus subtilis: Characterization and nutritive significance for promoting plant growth in Zea mays L. Dose-Response 2020, 18, 1559325820958911. [Google Scholar] [CrossRef] [PubMed]
- Akpomie, K.G.; Ghosh, S.; Gryzenhout, M.; Conradie, J. One-pot synthesis of zinc oxide nanoparticles via chemical precipitation for bromophenol blue adsorption and the antifungal activity against filamentous fungi. Sci. Rep. 2021, 11, 8305. [Google Scholar] [CrossRef] [PubMed]
- González-Merino, A.M.; Hernández-Juárez, A.; Betancourt-Galindo, R.; Ochoa-Fuentes, Y.M.; Valdez-Aguilar, L.A.; Limón-Corona, M.L. Antifungal activity of zinc oxide nanoparticles in Fusarium oxysporum-Solanum lycopersicum pathosystem under controlled conditions. J. Phytopathol. 2021, 169, 533–544. [Google Scholar] [CrossRef]
- Pillai, A.M.; Sivasankarapillai, V.S.; Rahdar, A.; Joseph, J.; Sadeghfar, F.; Rajesh, K.; Kyzas, G.Z. Green synthesis and characterization of zinc oxide nanoparticles with antibacterial and antifungal activity. J. Mol. Struct. 2020, 1211, 128107. [Google Scholar] [CrossRef]
- Gur, T.; Meydan, I.; Seckin, H.; Bekmezci, M.; Sen, F. Green synthesis, characterization and bioactivity of biogenic zinc oxide nanoparticles. Environ. Res. 2022, 204, 111897. [Google Scholar] [CrossRef] [PubMed]
- Alagumuthu, G.; Kirubha, R. Green synthesis of silver nanoparticles using Cissus quadrangularis plant extract and their antibacterial activity. Int. J. Nanomater. Biostruct. 2012, 2, 30–33. [Google Scholar]
- Nazir, A.; Raza, M.; Abbas, M.; Abbas, S.; Ali, A.; Ali, Z.; Younas, U.; Al-Mijalli, S.H.; Iqbal, M. Microwave assisted green synthesis of ZnO nanoparticles using Rumex dentatus leaf extract: Photocatalytic and antibacterial potential evaluation. Z. Für Phys. Chem. 2022, 236, 1203–1217. [Google Scholar] [CrossRef]
- Umavathi, S.; Mahboob, S.; Govindarajan, M.; Al-Ghanim, K.A.; Ahmed, Z.; Virik, P.; Al-Mulhm, N.; Subash, M.; Gopinath, K.; Kavitha, C. Green synthesis of ZnO nanoparticles for antimicrobial and vegetative growth applications: A novel approach for advancing efficient high quality health care to human wellbeing. Saudi J. Biol. Sci. 2021, 28, 1808–1815. [Google Scholar] [CrossRef]
- Nair, R.M.; Pandey, A.K.; War, A.R.; Hanumantharao, B.; Shwe, T.; Alam, A.; Pratap, A.; Malik, S.R.; Karimi, R.; Mbeyagala, E.K. Biotic and abiotic constraints in mungbean production—Progress in genetic improvement. Front. Plant Sci. 2019, 10, 1340. [Google Scholar] [CrossRef] [PubMed]
- Ullah, A.; Shah, T.M.; Farooq, M. Pulses production in Pakistan: Status, constraints and opportunities. Int. J. Plant Prod. 2020, 14, 549–569. [Google Scholar] [CrossRef]
- Herridge, D.F.; Robertson, M.J.; Cocks, B.; Peoples, M.B.; Holland, J.F.; Heuke, L. Low nodulation and nitrogen fixation of mungbean reduce biomass and grain yields. Aust. J. Exp. Agric. 2005, 45, 269–277. [Google Scholar] [CrossRef]
- Maryam Shahzady, H.; Ahmad, T.; Moosa, A.; Khan, W.A.; Naeem, I.; Nasir, M.; Aslam Khan, M.; Abbas, A.A. General review of cercospora leaf spot disease of mungbean and its management. Int. J. Sci. Footpr. 2017, 5, 81–84. [Google Scholar]
- Abbas, H.; Iqbal, M.A.; Kamran, M.; Shahbaz, M.U.; Kamber, H.U.; Javed, N.; Junaid, M.; Abbas, H.; ul Haq, M.E. Evaluation of advanced mung bean germplasm against Cercospora leaf spot and its in-vitro management by different fungicides. Pak. J. Agric. Res. 2020, 33, 872–877. [Google Scholar] [CrossRef]
- Dorman, H.D.; Deans, S.G. Antimicrobial agents from plants: Antibacterial activity of plant volatile oils. J. Appl. Microbiol. 2000, 88, 308–316. [Google Scholar] [CrossRef]
- Mohamed, A.A.; Salah, M.M.; El-Dein, M.M.Z.; El-Hefny, M.; Ali, H.M.; Farraj, D.A.A.; Hatamleh, A.A.; Salem, M.Z.M.; Ashmawy, N.A. Ecofriendly bioagents, Parthenocissus quinquefolia, and Plectranthus neochilus extracts to control the early blight pathogen (Alternaria solani) in tomato. Agronomy 2021, 11, 911. [Google Scholar] [CrossRef]
- Pachaiappan, R.; Rajendran, S.; Ramalingam, G.; Vo, D.-V.N.; Priya, P.M.; Soto-Moscoso, M. Green synthesis of zinc oxide nanoparticles by Justicia adhatoda leaves and their antimicrobial activity. Chem. Eng. Technol. 2021, 44, 551–558. [Google Scholar] [CrossRef]
- Tryfon, P.; Kamou, N.N.; Mourdikoudis, S.; Karamanoli, K.; Menkissoglu-Spiroudi, U.; Dendrinou-Samara, C. CuZn and ZnO nanoflowers as nano-fungicides against Botrytis cinerea and Sclerotinia sclerotiorum: Phytoprotection, translocation, and impact after foliar application. Materials 2021, 14, 7600. [Google Scholar] [CrossRef]
- Gong, X.; Liu, C.; Dang, K.; Wang, H.; Du, W.; Qi, H.; Jiang, Y.; Feng, B. Mung bean (Vigna radiata L.) source leaf adaptation to shading stress affects not only photosynthetic physiology metabolism but also control of key gene expression. Front. Plant Sci. 2022, 13, 36. [Google Scholar] [CrossRef] [PubMed]
- Alam, M.K.; Rana, Z.H.; Islam, S.N. Comparison of the proximate composition, total carotenoids and total polyphenol content of nine orange-fleshed sweet potato varieties grown in Bangladesh. Foods 2016, 5, 64. [Google Scholar] [CrossRef] [PubMed]
- Onofri, A.; Pannacci, E. Spreadsheet tools for biometry classes in crop science programmes. Commun. Biometry Crop Sci. 2014, 9, 43–53. [Google Scholar]
- Chandrappa, K.G.; Venkatesha, T.V. Electrochemical synthesis and photocatalytic property of zinc oxide nanoparticles. Nano-Micro Lett. 2012, 4, 14–24. [Google Scholar] [CrossRef]
- Fageria, P.; Gangopadhyay, S.; Pande, S. Synthesis of ZnO/Au and ZnO/Ag nanoparticles and their photocatalytic application using UV and visible light. Rsc Adv. 2014, 4, 24962–24972. [Google Scholar] [CrossRef]
- Padalia, H.; Chanda, S. Characterization, antifungal and cytotoxic evaluation of green synthesized zinc oxide nanoparticles using Ziziphus nummularia leaf extract. Artif. Cells Nanomed. Biotechnol. 2017, 45, 1751–1761. [Google Scholar] [CrossRef]
- Jamdagni, P.; Khatri, P.; Rana, J.S. Green synthesis of zinc oxide nanoparticles using flower extract of Nyctanthes arbor-tristis and their antifungal activity. J. King Saud Univ.-Sci. 2018, 30, 168–175. [Google Scholar] [CrossRef]
- Archana, P.; Janarthanan, B.; Bhuvana, S.; Rajiv, P.; Sharmila, S. Concert of zinc oxide nanoparticles synthesized using Cucumis melo by green synthesis and the antibacterial activity on pathogenic bacteria. Inorg. Chem. Commun. 2022, 137, 109255. [Google Scholar]
- Abomuti, M.A.; Danish, E.Y.; Firoz, A.; Hasan, N.; Malik, M.A. Green synthesis of zinc oxide nanoparticles using salvia officinalis leaf extract and their photocatalytic and antifungal activities. Biology 2021, 10, 1075. [Google Scholar] [CrossRef]
- Gupta, M.; Tomar, R.S.; Kaushik, S.; Mishra, R.K.; Sharma, D. Effective antimicrobial activity of green ZnO nano particles of Catharanthus roseus. Front. Microbiol. 2018, 9, 2030. [Google Scholar] [CrossRef]
- Zouirech, O.; Alyousef, A.A.; El Barnossi, A.; El Moussaoui, A.; Bourhia, M.; Salamatullah, A.M.; Ouahmane, L.; Giesy, J.P.; Aboul-Soud, M.A.; Lyoussi, B.; et al. Phytochemical analysis and antioxidant, antibacterial, and antifungal effects of essential oil of black caraway (Nigella sativa L.) seeds against drug-resistant clinically pathogenic microorganisms. BioMed Res. Int. 2022, 2022, 5218950. [Google Scholar] [CrossRef]
- Abo-Atya, D.M.; El-Mallah, M.F.; El-Seedi, H.R.; Farag, M.A. Novel prospective of N. sativa essential oil analysis, culinary and medicinal uses. In Black Cumin (Nigella sativa) Seeds: Chemistry, Technology, Functionality, and Applications; Springer: Cham, Switzerland, 2021; pp. 97–129. [Google Scholar]
- Majeed, A.; Muhammad, Z.; Ahmad, H.; Hayat, S.S.S.; Inayat, N.; Siyyar, S. Nigella sativa L.: Uses in traditional and contemporary medicines—An overview. Acta Ecol. Sin. 2021, 41, 253–258. [Google Scholar] [CrossRef]
- Lee, S.; Chung, H.; Kim, S.; Lee, I. The Genotoxic Effect of ZNO and CUO Nanoparticles on Early Growth of Buckwheat, Fagopyrum Esculentum. Water Air Soil Pollut. 2013, 224, 1668. [Google Scholar] [CrossRef]
- Liu, L.; Nian, H.; Lian, T. Plants and Rhizospheric Environment: Affected by Zinc Oxide Nanoparticles (ZnO NPs). A Review. Plant Physiol. Biochem. 2022, 185, 91–100. [Google Scholar] [CrossRef] [PubMed]
- Rajput, V.D.; Minkina, T.; Fedorenko, A.; Chernikova, N.; Hassan, T.; Mandzhieva, S.; Sushkova, S.; Lysenko, V.; Soldatov, M.A.; Burachevskaya, M. Effects of Zinc Oxide Nanoparticles on Physiological and Anatomical Indices in Spring Barley Tissues. Nanomaterials 2021, 11, 1722. [Google Scholar] [CrossRef] [PubMed]
- Aftab, A.; Yousaf, Y.; Javaid, A.; Riaz, N.; Younas, A.; Rashid, M.; Shamsher, B.; Arif, A. Antifungal activity of vegetative methanolic extracts of Nigella sativa against Fusarium oxysporum and Macrophomina phaseolina and its phytochemical profiling by GC-MS analysis. Int. J. Agric. Biol. 2019, 21, 569–576. [Google Scholar]
- Almshawit, H.; Macreadie, I. Fungicidal effect of thymoquinone involves generation of oxidative stress in Candida glabrata. Microbiol. Res. 2017, 195, 81–88. [Google Scholar] [CrossRef] [PubMed]
- Raval, B.P.; Shah, T.G.; Suthar, M.P.; Ganure, A.L. Screening of Nigella sativa seeds for antifungal activity. Ann. Biol. Res. 2010, 1, 164–171. [Google Scholar]
- Ashwini, J.; Aswathy, T.R.; Rahul, A.B.; Thara, G.M.; Nair, A.S. Synthesis and characterization of zinc oxide nanoparticles using Acacia caesia bark extract and its photocatalytic and antimicrobial activities. Catalysts 2021, 11, 1507. [Google Scholar] [CrossRef]
- He, L.; Liu, Y.; Mustapha, A.; Lin, M. Antifungal activity of zinc oxide nanoparticles against Botrytis cinerea and Penicillium expansum. Microbiol. Res. 2011, 166, 207–215. [Google Scholar] [CrossRef]
- Król, A.; Pomastowski, P.; Rafińska, K.; Railean-Plugaru, V.; Buszewski, B. Zinc oxide nanoparticles: Synthesis, antiseptic activity and toxicity mechanism. Adv. Colloid Interface Sci. 2017, 249, 37–52. [Google Scholar] [CrossRef] [PubMed]
- Rafiq, H.; Aftab, Z.-e.-H.; Anjum, T.; Ali, B.; Akram, W.; Bashir, U.; Mirza, F.S.; Aftab, M.; Ali, M.D.; Li, G. Bio-fabrication of Zinc Oxide nanoparticles to rescue Mung Bean against Cercospora leaf spot disease. Front. Plant Sci. 2022, 13, 4743. [Google Scholar] [CrossRef] [PubMed]
- Ouzakar, S.; Senhaji, N.S.; Saidi, M.Z.; El Hadri, M.; El Baaboua, A.; El Harsal, A.; Abrini, J. Antibacterial and antifungal activity of zinc oxide nanoparticles produced by Phaeodactylum tricornutum cultures and their potential application to extend the shelf life of sweet cherry (Prunus avium L.). Biocatal. Agric. Biotechnol. 2023, 49, 102666. [Google Scholar] [CrossRef]
- Ali, M.; Wang, X.; Haroon, U.; Chaudhary, H.J.; Kamal, A.; Ali, Q.; Saleem, M.H.; Usman, K.; Alatawi, A.; Ali, S. Antifungal activity of Zinc nitrate derived nano Zno fungicide synthesized from Trachyspermum ammi to control fruit rot disease of grapefruit. Ecotoxicol. Environ. Saf. 2022, 233, 113311. [Google Scholar] [CrossRef] [PubMed]
- Kamal, A.; Saba, M.; Kamal, A.; Batool, M.; Asif, M.; Al-Mohaimeed, A.M.; Al Farraj, D.A.; Habib, D.; Ahmad, S. Bioinspired Green Synthesis of Bimetallic Iron and Zinc Oxide Nanoparticles Using Mushroom Extract and Use Against Aspergillus niger; The Most Devastating Fungi of the Green World. Catalysts 2023, 13, 400. [Google Scholar] [CrossRef]
- Abdelaziz, A.M.; Salem, S.S.; Khalil, A.M.A.; El-Wakil, D.A.; Fouda, H.M.; Hashem, A.H. Potential of biosynthesized zinc oxide nanoparticles to control Fusarium wilt disease in eggplant (Solanum melongena) and promote plant growth. BioMetals 2022, 35, 601–616. [Google Scholar] [CrossRef]
- T-Thienprasert, N.P.; T-Thienprasert, J.; Ruangtong, J.; Jaithon, T.; Srifah Huehne, P.; Piasai, O. Large scale synthesis of green synthesized zinc oxide nanoparticles from banana peel extracts and their inhibitory effects against Colletotrichum sp., isolate KUFC 021, causal agent of anthracnose on dendrobium orchid. J. Nanomater. 2021, 2021, 5625199. [Google Scholar] [CrossRef]
- Subbaiah, L.V.; Prasad, T.N.V.K.V.; Krishna, T.G.; Sudhakar, P.; Reddy, B.R.; Pradeep, T. Novel effects of nanoparticulate delivery of zinc on growth, productivity, and zinc biofortification in maize (Zea mays L.). J. Agric. Food Chem. 2016, 64, 3778–3788. [Google Scholar] [CrossRef]
- Prasad, T.N.V.K.V.; Sudhakar, P.; Sreenivasulu, Y.; Latha, P.; Munaswamy, V.; Reddy, K.R.; Sreeprasad, T.S.; Sajanlal, P.R.; Pradeep, T. Effect of nanoscale zinc oxide particles on the germination, growth and yield of peanut. J. Plant Nutr. 2012, 35, 905–927. [Google Scholar] [CrossRef]
- Khan, M.A.; Yasmin, H.; Shah, Z.A.; Rinklebe, J.; Alyemeni, M.N.; Ahmad, P. Co application of biofertilizer and zinc oxide nanoparticles upregulate protective mechanism culminating improved arsenic resistance in maize. Chemosphere 2022, 294, 133796. [Google Scholar] [CrossRef] [PubMed]
- Ahmad, P.; Alyemeni, M.N.; Al-Huqail, A.A.; Alqahtani, M.A.; Wijaya, L.; Ashraf, M.; Kaya, C.; Bajguz, A. Zinc Oxide Nanoparticles Application Alleviates Arsenic (As) Toxicity in Soybean Plants by Restricting the Uptake of As and Modulating Key Biochemical Attributes, Antioxidant Enzymes, Ascorbate-Glutathione Cycle and Glyoxalase System. Plants 2020, 9, 825. [Google Scholar] [CrossRef] [PubMed]
- Kareem, H.A.; Saleem, M.F.; Saleem, S.; Rather, S.A.; Wani, S.H.; Siddiqui, M.H.; Alamri, S.; Kumar, R.; Gaikwad, N.B.; Guo, Z. Zinc oxide nanoparticles interplay with physiological and biochemical attributes in terminal heat stress alleviation in mungbean (Vigna radiata L.). Front. Plant Sci. 2022, 13, 101. [Google Scholar] [CrossRef] [PubMed]

| Serial Number | Treatments | Label |
|---|---|---|
| 1 | Negative control (without ZnO NPs treatment) | T1 |
| 2 | Positive control (Only Pathogen) | T2 |
| 3 | ZnO NPs solution (900 mg/L) | T3 |
| 4 | ZnO NPs solution (1200 mg/L) | T4 |
| 5 | ZnO NPs solution (900 mg/L) + C. canescens | T5 |
| 6 | ZnO NPs solution (1200 mg/L) + C. canescens | T6 |
| GO NPs Treatments (mg/L) | Shoot Length (cm) | Root Length (cm) | Number of Leaves (n) | Number of Pods per Plant (n) | No of Seeds per Pod (n) | Pod Size (cm) | Shoot Fresh Weight (g) | Shoot Dry Weight (g) | Root Fresh Weight (g) | Root Dry Weight (g) | Root Nodules (n) | Pod Fresh Weight (g) | Pod Dry Weight (g) |
|---|---|---|---|---|---|---|---|---|---|---|---|---|---|
| T1 | 34.13 ± 0.472 b | 14.03 ± 0.470 b | 22.0 ± 0.577 b | 8.00 ± 0.577 bc | 8.00 ± 0.577 abc | 7.00 ± 0.072 bc | 14.63 ± 0.504 ab | 4.30 ± 0.115 b | 1.36 ± 0.031 b | 0.48 ± 0.005 b | 12.6 ± 0.667 b | 1.30 ± 0.057 bc | 0.51 ± 0.022 bc |
| T2 | 18.57 ± 0.857 d | 6.47 ± 0.857 d | 12.0 ± 1.154 c | 5.67 ± 0.577 d | 5.67 ± 0.333 c | 4.93 ± 0.233 d | 7.70 ± 0.550 d | 2.07 ± 0.059 c | 0.72 ± 0.046 d | 0.20 ± 0.012 d | 7.33 ± 0.67 d | 0.89 ± 0.080 e | 0.35 ± 0.032 e |
| T3 | 37.31 ± 0.380 a | 17.21 ± 0.369 a | 25.0 ± 1.000 ab | 9.33 ± 0.333 ab | 10.0 ± 1.154 ab | 7.76 ± 0.145 ab | 15.6 ± 0.264 a | 6.05 ± 0.115 a | 1.51 ± 0.012 a | 0.57 ± 0.045 a | 14.0 ± 1.00 a | 1.49 ± 0.037 ab | 0.59 ± 0.014 ab |
| T4 | 38.41 ± 0.240 a | 18.31 ± 0.251 a | 27.3 ± 0.333 a | 11.0 ± 0.577 a | 11.0 ± 1.000 a | 7.86 ± 0.185 a | 15.9 ± 0.152 a | 6.17 ± 0.088 a | 1.54 ± 0.011 a | 0.58 ± 0.044 a | 15.0 ± 0.57 a | 1.65 ± 0.032 a | 0.65 ± 0.012 a |
| T5 | 31.47 ± 0.548 c | 11.37 ± 0.634 c | 22.0 ± 0.577 b | 6.67 ± 0.333 c | 7.0 ± 0.577 c | 6.40 ± 0.360 c | 12.52 ± 0.306 c | 4.00 ± 0.102 b | 1.20 ± 0.029 c | 0.42 ± 0.010 c | 9.33 ± 1.20 c | 1.09 ± 0.037 ce | 0.43 ± 0.014 ce |
| T6 | 33.33 ± 0.448 bc | 13.23 ± 0.692 bc | 22.3 ± 0.667 b | 7.33 ± 0.667 bc | 8.67 ± 0.333 abc | 6.96 ± 0.070 bc | 14.0 ± 0.173 b | 4.17 ± 0.202 b | 1.35 ± 0.015 b | 0.47 ± 0.005 b | 11.6 ± 0.88 b | 1.29 ± 0.023 bcd | 0.51 ± 0.009 bcd |
| Treatments (mg/L) | Chl a | Chl b | Total Chlorophyll | Carotenoids |
|---|---|---|---|---|
| T1 | 0.43145 ± 0.0184 b | 0.25473 ± 0.0062 b | 0.68619 ± 0.0216 b | 15.7123 ± 0.2312 ab |
| T2 | 0.32140 ± 0.0241 c | 0.17106 ± 0.0052 c | 0.49247 ± 0.0266 c | 11.3025 ± 0.5230 c |
| T3 | 0.54808 ± 0.0265 a | 0.31245 ± 0.0101 a | 0.86054 ± 0.0184 a | 16.0469 ± 0.8498 ab |
| T4 | 0.55238 ± 0.0123 a | 0.32789 ± 0.0035 a | 0.88027 ± 0.0162 a | 17.4531 ± 1.1536 a |
| T5 | 0.39641 ± 0.0117 bc | 0.22414 ± 0.0091 b | 0.62056 ± 0.0008 b | 13.4327 ± 1.1877 bc |
| T6 | 0.41742 ± 0.0112 b | 0.23704 ± 0.0082 b | 0.65447 ± 0.0212 b | 14.0980 ± 0.8630 abc |
Disclaimer/Publisher’s Note: The statements, opinions and data contained in all publications are solely those of the individual author(s) and contributor(s) and not of MDPI and/or the editor(s). MDPI and/or the editor(s) disclaim responsibility for any injury to people or property resulting from any ideas, methods, instructions or products referred to in the content. |
© 2025 by the authors. Licensee MDPI, Basel, Switzerland. This article is an open access article distributed under the terms and conditions of the Creative Commons Attribution (CC BY) license (https://creativecommons.org/licenses/by/4.0/).
Share and Cite
Aftab, Z.-e.-H.; Mirza, F.S.; Anjum, T.; Rizwana, H.; Akram, W.; Aftab, M.; Ali, M.D.; Li, G. Antifungal Potential of Biogenic Zinc Oxide Nanoparticles for Controlling Cercospora Leaf Spot in Mung Bean. Nanomaterials 2025, 15, 143. https://doi.org/10.3390/nano15020143
Aftab Z-e-H, Mirza FS, Anjum T, Rizwana H, Akram W, Aftab M, Ali MD, Li G. Antifungal Potential of Biogenic Zinc Oxide Nanoparticles for Controlling Cercospora Leaf Spot in Mung Bean. Nanomaterials. 2025; 15(2):143. https://doi.org/10.3390/nano15020143
Chicago/Turabian StyleAftab, Zill-e-Huma, Faisal Shafiq Mirza, Tehmina Anjum, Humaira Rizwana, Waheed Akram, Muzamil Aftab, Muhammad Danish Ali, and Guihua Li. 2025. "Antifungal Potential of Biogenic Zinc Oxide Nanoparticles for Controlling Cercospora Leaf Spot in Mung Bean" Nanomaterials 15, no. 2: 143. https://doi.org/10.3390/nano15020143
APA StyleAftab, Z.-e.-H., Mirza, F. S., Anjum, T., Rizwana, H., Akram, W., Aftab, M., Ali, M. D., & Li, G. (2025). Antifungal Potential of Biogenic Zinc Oxide Nanoparticles for Controlling Cercospora Leaf Spot in Mung Bean. Nanomaterials, 15(2), 143. https://doi.org/10.3390/nano15020143

